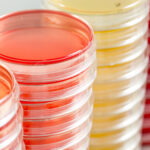
PREPARED CULTURE MEDIA

well recognized by the business community for our enduring values, integrity and quality of service
We will continue to lead the way by providing innovative business solutions to meet our customers’
in emerging healthcare sector of Bahrain.






OUR STORY
We started out with an initial focus on the rapidly developing Bahraini market, the emergent investment profile, and the positive steps taken by the Bahraini leadership to attract foreign investors. While catering to the demands from our clients, as we evolved, and exploring new horizons of the emergence of the Medical Equipment Division. This division is vital to our company. We are committed to representing state of the art medical technology and equipment so as to benefit the citizens of the Kingdom of Bahrain.
OUR MESSAGE
WMS believes that success lies within the company’s vision. Years of dedicated effort have enabled WMS to build and maintain a diverse portfolio of businesses that present enumerable growth opportunities and a stable base of sustainable returns. Diligent efforts have rewarded the group well, as the company has established itself as a premier integrated investment group with strong footing in Healthcare sector. We have our own Medical Laboratory/s and Health centers as they were our main purpose since 1996. We seek to abide by the key principles of client accountability, responsible stewardship, professionalism, efficiency and transparency. Our client-driven strategy is guided by quality, creative solutions and a never-ending search for better ways to serve clients.
VISION
In line with the leadership vision 2030 we wish to be a prominent company in the Kingdom of Bahrain, and well recognized by the business community for our enduring values, integrity and quality of service.
MISSION
Our steadfast commitment to professional and diversified services, have truly benefited our customers. We will continue to lead the way by providing innovative business solutions to meet our customers’ in emerging healthcare sector of Bahrain.